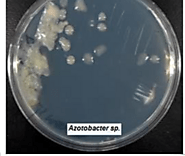
Azotobacter agar plate

-
About
- About Listly
- Community & Support
- Howto
- Chrome Extension
- Bookmarklet
- WordPress Plugin
- Listly Premium
- Privacy
- Terms
- DMCA Copyright
- © 2010-2025 Boomy Labs


Listly by 223032830
Meet Azotobacter chroococcum, a tiny bacterium with a big job! It takes nitrogen from the air and turns it into a form plants can use, boosting soil fertility and promoting plant growth. Found in soil and water, this little powerhouse helps farmers reduce chemical fertilizers. A true superhero in the world of microbes! 🌱💪

Azotobacter chroococcum is a free-living, nitrogen-fixing bacterium known for converting atmospheric nitrogen into usable form for plants. It is the most dominant species within the Azotobacter genus and typically thrives in neutral to alkaline soil or aquatic environments. The Dutch microbiologist Martinus Beijerinck first discovered this bacterium in 1901 and identified it as the first aerobic, free-living nitrogen fixer.

Azotobacter chroococcum is widely used as a biofertilizer for crops, this helps in reducing environmental pollution by decreasing the reliance on chemical nitrogen fertilizers. The bacterium produces auxins which simulate plant growth. A.chroococcum is also a probiotic. A. chroococcum can assist in cleaning up oil spills and detoxifying heavy metals in contaminated soils. Its ability to produce melanin helps protect its nitrogenase system from oxygen, facilitating survival in polluted environments.

A. chroococcum is a gram-negative, bacillus-shaped bacterium that is obligate aerobic, heterotrophic, and non-symbiotic. It can move for 48 hours due to its flagella and has a positive interaction with PGPR making it significant for soil fertility and plant growth.it fixes atmospheric nitrogen under aerobic conditions and converts it into ammonia. It synthesizes enzymes to neutralize reactive oxygen species, which facilitates the nitrogen fixation process.

A.chroococcum can degrade various organic pollutants, and can be used in bioremediation projects to clean up contaminated environments oil spills and agricultural runoff. This bacterium is crucial for nutrient recycling , it removes harmful toxins and maintains soil health. a.chroococcum has a mutualistic relationship with plants, helping them by providing them with fixed nitrogen and protecting them from diseases and the plant will help the bacterium by providing it with carbohydrates

Habitat destruction and pollution threaten A.chroococcum populations. Industrial agriculture, heavy pesticide use, and synthetic fertilizers can harm the bacterium's ability to thrive in soil ecosystems. While this microorganism has potential in biotechnology, concerns about genetic modification must be addressed due to possible ecological consequences. To maintain ecological balance, sustainable practices in the use of Azotobacter chroococcum for biofertilization and other applications are essential.
Taxonomy and Classification
Kingdom : Bacteria
Phylum : Proteobacteria
Class : Alpha Proteobacteria
Order : Rhizobiales
Family : Azotobacteraceae
Genus : Azotobacter
Species : chroococcum